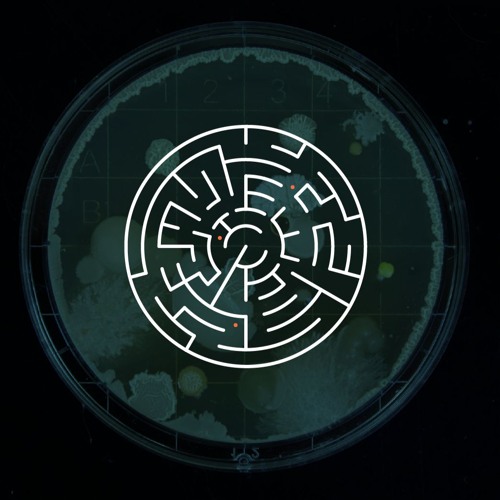

Local Disturbances - Shorts #34 - Talking With and Through Generative Text
UKAI Projects
52
8:46
Jun 3, 2024
In this episode of Local Disturbances, we delve into the intricate world of generative text and its place in prose art. Drawing inspiration from Mikhail Bakhtin's concept of "artistically representing language," we explo…




